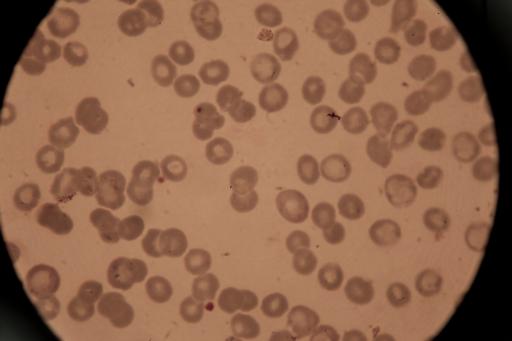

Journée mondiale du paludisme : cinq défis dans la lutte contre la maladie
Bien que le nombre de cas et de décès liés au paludisme soit en constante diminution depuis 15 ans, cette maladie continue d’être à l’origine de plus de 400 000 décès chaque année, essentiellement en Afrique (90% des décès) et chez les enfants (70% des décès).Mieux prévenir, diagnostiquer et soigner, limiter la propagation du parasite : pour pouvoir faire face aux multiples défis que pose la maladie, la lutte contre le paludisme doit combiner plusieurs stratégies.
1. L’impact des phénomènes climatiques
En 2012, 2014 et 2015, les équipes MSF ont fait face à des pics notables de la maladie dans plusieurs pays d’Afrique sub-saharienne, comme la République démocratique du Congo (RDC), la République centrafricaine (RCA), le Soudan du Sud, l’Ouganda ou encore le Mali. Ainsi à Yida, au Soudan du Sud, le nombre de cas de paludisme soignés dans les dispensaires de MSF a quasiment triplé entre 2014 et 2015 (de 7 500 à environ 20 000 cas pris en charge).
Si les raisons de cette augmentation sont complexes et parfois spécifiques, le rôle d’el Niño, phénomène climatique à l’origine d’une augmentation de la température et de la pluviométrie, semble important. Ces anomalies climatiques ont aussi eu pour effet d’augmenter le nombre de cas de paludisme dans des régions jusque-là épargnées.

© Lexie Cole/MSF
2. La résistance aux insecticides
La lutte anti-vectorielle, composante essentielle des stratégies de contrôle du paludisme, vise à réduire l’exposition des personnes aux piqûres de moustiques grâce à l’utilisation de moustiquaires imprégnées d’insecticide, la pulvérisation d’insecticides dans et autour des habitations et l’élimination des larves de l’insecte, entre autres.
Selon l’Organisation mondiale de la Santé (OMS), en 2014, plus de la moitié de la population africaine avait accès à une moustiquaire, contre 2% en 2000. Cependant, le niveau de résistance des moustiques aux pyréthrinoïdes, principaux insecticides utilisés pour imprégner les moustiquaires, est en augmentation. Bien que la documentation sur ce phénomène reste fragmentaire, une réduction de l’efficacité de ces insecticides a été rapportée dans plusieurs pays où MSF intervient. Malgré ce constat, des moustiquaires imprégnées avec des produits dont l’efficacité est limitée continuent d’être commandées dans plusieurs pays où la maladie sévit.

© Ricardo Garcia Vilanova
3. La prévention : des stratégies efficaces, mais pas pérennes
En 2012, MSF a mis en place l’une des premières campagnes de chimio-prévention du paludisme saisonnier (CPS) à vaste échelle, au Mali et au Tchad. Depuis, cette stratégie a été intégrée dans les politiques nationales de 13 pays du Sahel et plus de 15 millions d’enfants de la région devraient en bénéficier en 2016.
La CPS, basée sur la distribution préventive aux enfants de traitements contre le paludisme pendant les mois de haute transmission de la maladie (les ‘pics’ saisonniers), a montré des résultats très encourageants : jusqu’à moins 80% de cas de paludisme simple et jusqu’à moins 70% pour les cas sévères. De plus, l’association de la CPS à d’autres activités médicales (dépistage et traitement de la malnutrition, vaccination) permet d’utiliser cette mise en contact avec un grand nombre d’enfants pour pouvoir lutter contre plusieurs causes de mortalité infantile en même temps.
Cependant, cette stratégie n’a pas vocation à devenir un outil permanent dans la lutte contre la maladie : l’impact de ces distributions reste limité dans le temps et cesse quelques semaines après leur arrêt.

© Miguel Cuenca / MSF
4. La résistance du parasite aux antipaludéens
Depuis 2001, l’OMS recommande l’utilisation des ACT (traitements combinés à base d’artémisinine, molécule issue de la médecine traditionnelle chinoise) comme traitement du paludisme. Les ACT venaient remplacer d’anciennes molécules (comme la chloroquine ou la sulphadoxine-pyriméthamine) devenues inefficaces car le plasmodium, parasite responsable du paludisme, y était de plus en plus résistant.
L’utilisation de ces nouveaux traitements a beaucoup participé à la réduction spectaculaire du nombre de décès liés au paludisme ces quinze dernières années. Mais, dès le milieu des années 2000, des résistances du parasite à l’artémisinine ont été documentées, notamment en Asie du Sud-Est, mais aussi en Amérique latine. L'utilisation de monothérapies (artémisinine seule, non-associée à d'autres molécules, de médicaments contrefaits ou de mauvaise qualité et les interruptions de traitement dès la disparition des symptômes accélèrent ce phénomène de résistances. Aucun traitement pouvant remplacer l’artémisinine n'étant disponible avant plusieurs années, la propagation de ces résistances représente donc un risque majeur de santé publique.

© Diana Zeyneb Alhindawi
5. La quête d’un vaccin efficace continue
Après des décennies de recherches infructueuses, le RTS,S (ou Mosquirix©) est le premier vaccin développé contre le paludisme à avoir complété son développement clinique. Cependant, son efficacité est limitée, notamment contre les formes sévères de la maladie, et son utilisation reste compliquée (administration de quatre doses et 18 mois doivent séparer la troisième et la dernière dose).
En octobre 2015, le groupe d’experts sur la vaccination de l’OMS (SAGE) a recommandé l’utilisation de ce vaccin dans des projets pilote et à petite échelle, afin de mieux en étudier les conditions d’utilisation. MSF n’a pour l’heure pas souhaité participer à ces recherches, estimant que l’introduction de ce vaccin dans des pays à faibles revenus serait trop compliquée au vu du faible taux de protection espéré et des faibles éléments disponibles quant à son innocuité.
MSF continue d’appeler à ce que la recherche pour la mise au point d’un vaccin sécure efficace, peu cher et facile à utiliser dans les pays en développement se poursuive.
© Martina Bacigalupo
En 2015, MSF a pris en charge environ 2 millions de cas de paludisme à travers le monde. Plus de 750 000 enfants ont également bénéficié d’une distribution de traitements à but préventif (CPS) au Niger, au Mali et au Tchad.
► Pour plus d'infos sur le paludisme, consultez notre page dédiée.
► Pour plus d'informations sur le paludisme, consultez notre page dédiée.